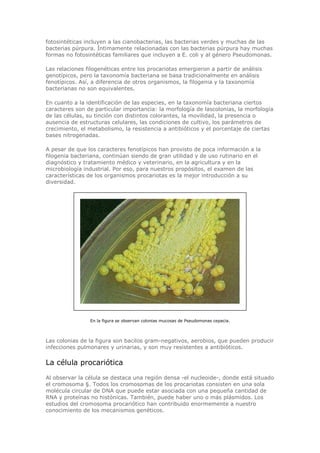
fotosintéticas incluyen a las cianobacterias, las bacterias verdes y muchas de las
bacterias púrpura. Íntimamente relacionadas con las bacterias púrpura hay muchas
formas no fotosintéticas familiares que incluyen a E. coli y al género Pseudomonas.
Las relaciones filogenéticas entre los procariotas emergieron a partir de análisis
genotípicos, pero la taxonomía bacteriana se basa tradicionalmente en análisis
fenotípicos. Así, a diferencia de otros organismos, la filogenia y la taxonomía
bacterianas no son equivalentes.
En cuanto a la identificación de las especies, en la taxonomía bacteriana ciertos
caracteres son de particular importancia: la morfología de lascolonias, la morfología
de las células, su tinción con distintos colorantes, la movilidad, la presencia o
ausencia de estructuras celulares, las condiciones de cultivo, los parámetros de
crecimiento, el metabolismo, la resistencia a antibióticos y el porcentaje de ciertas
bases nitrogenadas.
A pesar de que los caracteres fenotípicos han provisto de poca información a la
filogenia bacteriana, continúan siendo de gran utilidad y de uso rutinario en el
diagnóstico y tratamiento médico y veterinario, en la agricultura y en la
microbiología industrial. Por eso, para nuestros propósitos, el examen de las
características de los organismos procariotas es la mejor introducción a su
diversidad.
En la figura se observan colonias mucosas de Pseudomonas cepacia.
Las colonias de la figura son bacilos gram-negativos, aerobios, que pueden producir
infecciones pulmonares y urinarias, y son muy resistentes a antibióticos.
La célula procariótica
Al observar la célula se destaca una región densa -el nucleoide-, donde está situado
el cromosoma §. Todos los cromosomas de los procariotas consisten en una sola
molécula circular de DNA que puede estar asociada con una pequeña cantidad de
RNA y proteínas no histónicas. También, puede haber uno o más plásmidos. Los
estudios del cromosoma procariótico han contribuido enormemente a nuestro
conocimiento de los mecanismos genéticos.

El documento discute la complejidad del estudio de la biología. Aborda temas como la migración de aves, la distribución de monos araña y la supervivencia de plantas en el desierto. Explica que los biólogos usan múltiples hipótesis para comprender fenómenos biológicos que involucran diversos factores. También señala que la biología es un objeto de estudio diverso y complejo que requiere considerar procesos a diferentes escalas espacio-temporales.










![Introducción / 9
dencias, Lamarck propuso que las formas más complejas habían surgi-
do de las formas más simples por un proceso de transformación pro-
gresiva.
Posteriormente, el geólogo inglés Charles Lyell (1797-1875),
apoyándose en la comparación de fósiles de distintas eras, dio un
vuelco en la concepción de la época. En su libro Principios de geo-
logía, publicado en 1830, Lyell expuso la teoría uniformitarista (ya
esbozada en 1788 por el geólogo escocés James Hutton [1726-
1797]) en la que sostenía que un efecto lento, constante y acumu-
lativo de las fuerzas naturales había producido un cambio continuo
en el curso de la historia de la Tierra. Las causas naturales que inter-
vienen actualmente y de una manera observable en la determina-
ción de los procesos geológicos son las mismas que siempre mode-
laron la superficie de la Tierra. Las ideas de Lyell inspiraron a Darwin
en su interpretación del mundo biológico.
Dos viajes que cambiaron el rumbo del pensamiento
Entre los siglos XVIII y XIX, los trabajos de dos grandes viajeros mar-
caron los cambios que sentaron las bases de la biología moderna. Uno
de ellos fue el geógrafo y físico alemán Alexander von Humboldt
(1769-1859). A partir de sus viajes surge un nuevo modelo de ciencia
natural, más centrado en las características del terreno de donde prove-
nían los especímenes recolectados que en una mera descripción de
esas especies. El objetivo era comparar y combinar los hechos observa-
dos. Humboldt analizó tanto la morfología de las plantas como la
dinámica de las interacciones de sus elementos (véase cap. 50, recua-
dro 50-1).
Desarrollaremos estos conceptos en la Sección 8: Ecología.
Humboldt ejerció una influencia profunda en un joven inglés que
había abandonado sus estudios de medicina para dedicarse ávidamen-
te a los de historia natural. Charles Darwin (1809-1882) había leído
con enorme interés los relatos del viaje de Humboldt a Tenerife (Islas
Canarias) y había decidido que él también recorrería esas islas. Pero la
propuesta de embarcarse a bordo del Beagle como naturalista no ofi-
cial cambió sus planes y el rumbo de la historia.
El viaje representó un hecho fundamental en la formación intelec-
tual de Darwin (1 fig. I-11). Mientras el Beagle descendía a lo largo
de la costa atlántica de Sudamérica, atravesaba el Estrecho de Magalla-
nes y ascendía por la costa del Pacífico (1 fig. I-12), Darwin viajaba
por el interior del continente y exploraba los Andes a pie y a caballo. Allí
observó distintos estratos geológicos, descubrió conchas marinas fósi-
les a aproximadamente 3.700 metros de altura y fue testigo del cata-
clismo terrestre producido por un gran terremoto. Además, coleccionó
ejemplares de numerosas plantas y animales desconocidos.
Darwin se impresionó fuertemente durante su largo y lento viaje,
a lo largo de una y otra costa, por las diferencias que observó entre las
distintas variedades de organismos. Las aves y otros animales de la cos-
ta oeste eran muy diferentes de los de la costa este, e incluso, a medi-
da que él ascendía lentamente por la costa occidental, una especie iba
siendo reemplazada por otra.
Aunque Darwin no fue el primero en proponer que los organis-
mos evolucionan, o cambian, a lo largo del tiempo, fue el primero en
acumular una cantidad importante de evidencia en apoyo de esta
idea y en proponer un mecanismo válido por el cual podría ocurrir la
evolución.
Volveremos sobre estos conceptos en la Sección 4: Evolución.
Después de Darwin
La teoría de Darwin se constituyó, así, en el principio fundamental
de la biología. En los siglos XIX y XX, otros principios –que en la actua-
lidad consideramos que subyacen en la Teoría de la Evolución– permi-
tieron que la biología se consolidara como ciencia:
• Entre 1838 y 1858 se estableció la idea de que todos los organismos
vivos están compuestos por una o más células y que éstas pueden
originarse exclusivamente a partir de células preexistentes. Este prin-
cipio universalmente aceptado se conoce como teoría celular. A me-
diados del siglo XIX comenzaron a realizarse estudios bioquímicos y
metabólicos siguiendo modelos experimentales cada vez más preci-
sos y rigurosos (1 fig. I-13).
Desarrollaremos estos conceptos en la Sección 1: Unidad de
la vida.
• En la segunda mitad del siglo XIX se comenzó a estudiar científica-
mente la herencia, es decir, la transmisión de las características de los
progenitores a los descendientes. En la actualidad, estos temas inves-
tigados por la genética moderna se encuentran entre los problemas
fundamentales de la biología contemporánea.
Desarrollaremos estos conceptos en la Sección 2: Genética:
bases celulares y químicas de la herencia y en la Sección 3: Los
genes en acción: estructura, expresión y control de la información
genética.
Además, se fue avanzando en los estudios anatómicos y fisiológi-
cos de plantas y animales. Poco a poco, los procesos del desarrollo se
Fig. I-11. CHARLES DARWIN EN 1840, CUATRO AÑOS DESPUÉS DE
REGRESAR DE SU VIAJE DE CINCO AÑOS EN EL H. M. S. BEAGLE.
Historia
de
la
biología
Evolución
-
1836](https://image.slidesharecdn.com/biologia-helena-curtis-231021203802-fc8dc6b6/85/Biologia-Helena-Curtis-pdf-11-320.jpg)